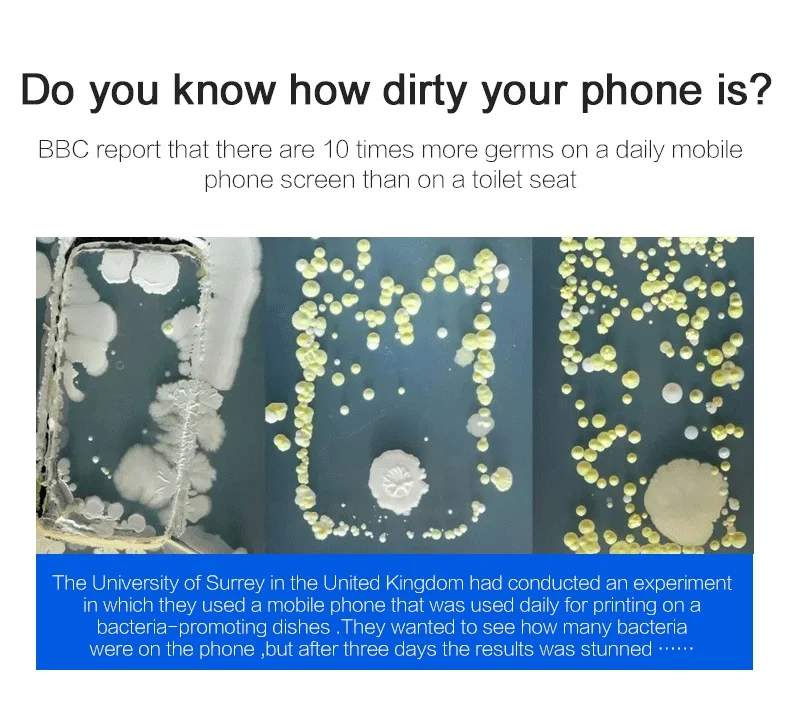

Трендовые продукты быстрая Беспроводная зарядка 5 Вт 10 usb Беспроводное зарядное устройство для сотового
- Категория: Mutifunction Chargers >>>
- Поставщик: Shenzhen,Bolaide,Technology,Co.,Ltd.
Поделиться:
Описание и отзывы
Трекер стоимости
| Месяц | Минимальная цена | Макс. стоимость |
|---|---|---|
| Aug-16-2025 | 906.11 $* | 924.33 $* |
| Jul-16-2025 | 734.42 $* | 749.15 $* |
| Jun-16-2025 | 891.60 $* | 909.67 $* |
| May-16-2025 | 884.92 $* | 902.36 $* |
| Apr-16-2025 | 706.8 $* | 720.45 $* |
| Mar-16-2025 | 870.27 $* | 887.62 $* |
| Feb-16-2025 | 863.32 $* | 880.45 $* |
| Jan-16-2025 | 856.8 $* | 873.50 $* |
Характеристики
Характеристики
| Наименование: | ODM |
| Usage: | chargers for smart phones |
| function2: | Wireless Charging mobile phone charger |
| Use: | Mobile Phone |
| Port: | USB cable |
| Выходное напряжение: | 5 В/2A |
| Мощность на выходе: | 8W,5 Вт |
| Модели: | WC1 |
| Name: | mutifunction wireless charger |
| Function: | wireless charging for iphone |
| Применение: | Профессиональный |
| Происхождение товара: | SHENZHEN |
| Сертификация: | RoHS fcc |
| Product name: | Wireless Charger |
| style: | type c charger |
| Многофункциональный агрегатная: | С лампой,С дополнительным внешним аккумулятором |
| Входное напряжение: | 9 В/2A |
| Certificate: | CE /FCC/Rohs |
| продажи Единиц: | Single item |
| одноместный размер пакета: | 16X17X16 cm |
| одноместный полная масса: | 1.2 KG |
Похожие товары
Данные ресурс не является интернет-магазином, а лишь содержит ссылки на международную торговую площадку Alibaba.com